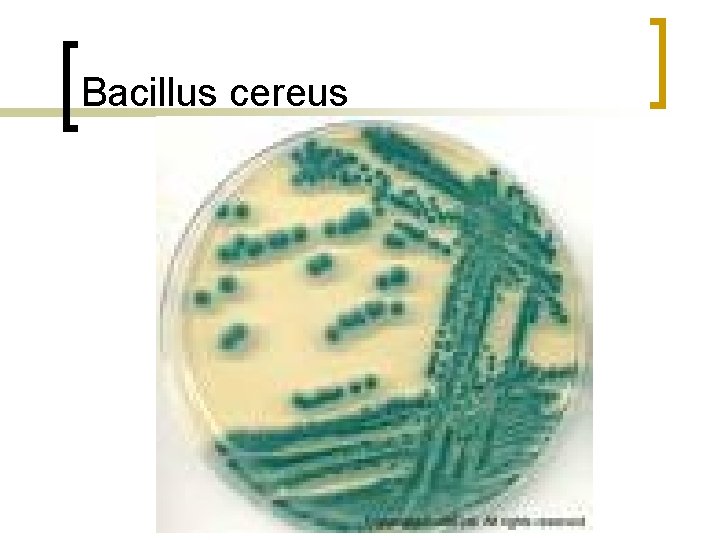
Bacillus cereus

Bacillus cinsi bakteriler n Dr Erdal Polat Bacillus

Bacillus cinsi bakteriler n Dr. Erdal Polat

Bacillus cinsi n Spor oluşturan Gram pozitif çomaklardır

Bacillus cinsi 1. 2 -8 / 0. 3 -22 µm n. Sporlu n. Isıya dirençli n. Gram pozitif n. Aerop n. Genellikle hareketli n. Bazen zincirler oluştururlar n

Bacillus cinsi

Bacillus cinsi n n n Havada Suda Tozlarda Dışkıda Toprakta bulunurlar

Bacillus cinsi n n n n B. anthracis B. cereus B. pumilus B. Subtilis (insanda hastalık oluştururlar) B. popilliae B. lentimorbus B. thuringiensis B. entomocidus (artropodlar ile mücadelede kullanılır)

Bacillus cinsi n n B. polymyxa B. pumilis sümüksü madde yaparlar (ekmek) B. coagulans B. stearothermophilus (konserveleri gaz yapmadan bozar ve otoklavların biyolojik kontrölünde kullanılır)

Bacillus anthracis n n n Hayvanlarda ve insanlarda şarbon hastalığını oluştururu İnsanlarda Deri Akciğer (inhilasyon) Sindirim sistemi şarbonunu oluşturur 2001 yılında ABD deri ve akciğer şarbonu görülmüştür

Bacillus anthracis n n n n 3 -8 / 1 -1. 5 µm Gram pozitif Kapsüllü (D-glutamat) Hareketsiz İki ucu düz olarak kesik Genellikle zincir olulturur ve birbiri ardından dizilince bambu kamışını andırır Sporlu

Bacillus anthracis

Bacillus anthracis

Bacillus anthracis

Bacillus anthracis n Fakültatif anaerop n Adi besiyerinde iyi ürer

Bacillus anthracis (İnsanlara bulaşması) n n n Hasta hayvanlarla temas Deri, gübre, kemik tozu, yemler, kıl ve yün gibi hayvan ürünlerindeki sporlar ile Sporların solunum yolundan alınmasıyla Sindirim siteminden laboratuarlarda

Bacillus anthracis (İnsanlara bulaşması)

Bacillus anthracis (İnsanlara bulaşması)

Bacillus anthracis (İnsanlara bulaşması)


Bacillus anthracis (İnsanlara bulaşması)

Patogenez n n Şarbon toksinleri neden olur Ekzotoksinler A. Ödenm faktörü; adenilat siklaz sıvının hücre içinden hücre dışına atılmasına neden olur ve ödem oluşturur B. Letal faktör; fosfokinazı yaran bir proteazdır. Fosfokinazın yarılması hücre üremesini inhibe eder

Patogenez n n n Hava ile alınan şarbon sporları Alveollerde büyük mononükler hücreler tarafından yutulur, bu yolla alveol çeperinden geçirilip limf yollarına ve limf düğümlerine yerleşir. Limf düğümlerinde kanamalı yangı ve nekroz gelişir.

Klinik bulgular n n Şarbonun kuluçka dönemi 1 -7 gün Deri Akciğer (inhilasyon) Sindirim sistemi şarbonunu

Deri şarbonu n n n En sık görülen şarbon türüdür Yerel ödem çok çarpıcıdır Lezyonun içi sarı veya kanlı sıvıyla dolu kabarcık “kara kabarcık”

Deri şarbonu

Deri şarbonu

Deri şarbonu




Akciğer şarbonu n n n n Yüksek ateş Nefes darlıği Morarma Halsizlik Öksürük Kanlı balgam Plevra boşluğuna sıvı toplanır

Akciğer şarbonu

Sindirim sistemi şarbonunu n n n Karın ağrısı Şişkinlik Kanlı sürgün Kanlı kusmalar Peritonit (Barsak delinmesi) Kollapstan hasta ölür

Ağızda şarbon

Laboratuar Tanısı n n Gram boyaması Kanlı agar

Laboratuar Tanısı

Laboratuar Tanısı

Laboratuar Tanısı

Laboratuar Tanısı

Tedavi n n n n Penicilin 500. 000 birim 2 X 1 (3 gün) Tetrasiklin Doksisiklin Spirofloksasin Kloramfehikol Erythromycin Sulfonamid

Korunma n n Profilaksi; Doksisiklin, Spirofloksasin Aşı

Bacillus cereus n n n 3 -5 / 1 -1. 2 µm Gram pozitif Kapsülsüz Hareketli İki ucu düz Sporlu

Bacillus cereus

Bacillus cereus

Bacillus cereus

Bacillus cereus n Besin zehirlenmelerine neden olur

Patogenez n n Adenilat siklazı uyaran enterotoksin; enterositler içindeki döngüsel adenozin monofosfat (AMP) erişiminde bir artışa yol açan bir G protenine, ADPribozillenem ile adenozin difosfata ribozu ekler. Stafilokok entero toksinlerine benzer toksin

Bacillus cereus

Bacillus cereus

Klinik bulgular n n n Besin alındıktan 4 saat sonra Bulantı Kusma Besin alındıktan 18 saat sonra Sulu ve kansız ihsal

Bacillus cereus

Bacillus cereus

Bacillus cereus
Bacillus cereus

Bacillus cereus Bacillus anthracis Arasındaki farklar n n n n Hareketli Kapsülsüz Pencillin (10µ/ml) Ürer Kanlı agarda hemoliz yapar Gama fajlara duyarlı Turnusollu sütü 72 h peptonlaştırır Farelerde enfeksiyon oluşturmaz n Hareketsiz Kapsülü n Pencillin (10µ/ml) Üremez n Kanlı agarda hemoliz yapmaz Gama fajlara duyarsız Turnusollu sütü 72 h peptonlaştırmaz Farelerde enfeksiyon oluşturur n n
- Slides: 54